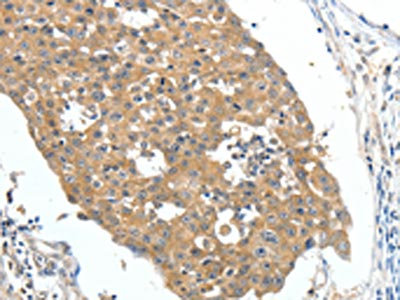

FSHR Antibody
-
中文名稱:FSHR兔多克隆抗體
-
貨號:CSB-PA288553
-
規格:¥1100
-
圖片:
-
The image on the left is immunohistochemistry of paraffin-embedded Human breast cancer tissue using CSB-PA288553(FSHR Antibody) at dilution 1/70, on the right is treated with fusion protein. (Original magnification: ×200)
-
The image on the left is immunohistochemistry of paraffin-embedded Human liver cancer tissue using CSB-PA288553(FSHR Antibody) at dilution 1/70, on the right is treated with fusion protein. (Original magnification: ×200)
-
-
其他:
產品詳情
-
Uniprot No.:
-
基因名:
-
別名:Follicle stimulating hormone receptor antibody; Follicle stimulating hormone receptor isoform 1 antibody; Follicle-stimulating hormone receptor antibody; Follitropin receptor antibody; FSH receptor antibody; FSH-R antibody; Fshr antibody; FSHR_HUMAN antibody; FSHRO antibody; LGR1 antibody; MGC141667 antibody; MGC141668 antibody; ODG1 antibody; ovarian dysgenesis 1 antibody
-
宿主:Rabbit
-
反應種屬:Human,Mouse,Rat
-
免疫原:Fusion protein of Human FSHR
-
免疫原種屬:Homo sapiens (Human)
-
標記方式:Non-conjugated
-
抗體亞型:IgG
-
純化方式:Antigen affinity purification
-
濃度:It differs from different batches. Please contact us to confirm it.
-
保存緩沖液:-20°C, pH7.4 PBS, 0.05% NaN3, 40% Glycerol
-
產品提供形式:Liquid
-
應用范圍:ELISA,IHC
-
推薦稀釋比:
Application Recommended Dilution ELISA 1:2000-1:5000 IHC 1:50-1:200 -
Protocols:
-
儲存條件:Upon receipt, store at -20°C or -80°C. Avoid repeated freeze.
-
貨期:Basically, we can dispatch the products out in 1-3 working days after receiving your orders. Delivery time maybe differs from different purchasing way or location, please kindly consult your local distributors for specific delivery time.
-
用途:For Research Use Only. Not for use in diagnostic or therapeutic procedures.
相關產品
靶點詳情
-
功能:G protein-coupled receptor for follitropin, the follicle-stimulating hormone. Through cAMP production activates the downstream PI3K-AKT and ERK1/ERK2 signaling pathways.
-
基因功能參考文獻:
- In the homozygous model (GG vs AA), the FSHRThr307Ala-Asn680Ser gene polymorphism might be a protective factor against male infertility. PMID: 29738186
- Results indicate the frequency distribution of the common follicle stimulating hormone receptor (FSHR) single-nucleotide polymorphisms (SNPs) in Mexican subjects of Hispanic origin. PMID: 30340493
- This study demonstrates that both gonadotrophin receptors9 FSH receptor (FSHR) and LH/choriogonadotrophin receptor (LHCGR) are expressed along the glandular epithelium of endometria and they mediate the effects of gonadotrophins on intracellular functions. PMID: 29974367
- rs6165 and rs6166 genotypes associated with in vitro fertilization outcome PMID: 29916276
- High FSHR expression is associated with polycystic ovary syndrome. PMID: 29626103
- The paper reviews the data concerning the appearance of ectopic FSHR in particular human neoplasms. The possible involvement of FSHR in tumor progression and the use of FSHR for diagnostic/therapeutic purposes is also reviewed. PMID: 29952426
- Data provide evidence that FSHR expression is regulated by BDNF which affects its expression and post-translational modifications in granulosa cells. PMID: 28282971
- we observed that a genetic variant associated with FSHR activity may modulate the susceptibility to testicular germ cell cancer PMID: 29179257
- The results herein suggest that the FSHR polymorphism N680S is significantly associated with preterm birth in a Mexican-Mestizo population. PMID: 28282771
- FSHR single nucleotide polymorphism is associated with poor ovarian response in Egyptian women undergoing IVF procedure. PMID: 28825151
- Findings suggest that 680Ser-Ser/GG genotype and "GG/307Ala680Ser" haplotype increase the risk of endometriosis in fertile women, while "GA/307Ala680Asn" haplotype decreases the risk of endometriosis development and progression. PMID: 29683332
- The FSHR -29G/A polymorphism modulates FSH and, for the first time, LH serum levels and body mass index in normozoospermic men. PMID: 28624859
- FSH-FSHR signaling was shown to promote HUVEC angiogenesis and thereafter suggested to have an influential role in pregnancy. PMID: 27848975
- the novel homozygous FSHR variant observed in 2 siblings with Hypergonadotropic hypogonadism can expand the spectrum of FSHR mutations in humans. PMID: 28591755
- Follicle-stimulating hormone receptor single nucleotide polymorphisms are not associated with male infertility. PMID: 28224403
- the expression levels of placental FSHR mRNA and protein were significantly decreased in pregnancies complicated by preeclampsia. PMID: 28534997
- Polymorphisms of the FSH receptor is associated with normal morphology and genetic maturation (metaphase II) oocytes in dependence of genotypic variation polymorphisms. PMID: 27994298
- T cells redirected against FSHR(+) tumor cells with full-length FSH represent a promising therapeutic alternative against a broad range of ovarian malignancies, with negligible toxicity even in the presence of cognate targets in tumor-free ovaries PMID: 27435394
- Findings of this study suggest a significant association between FSHR gene p. Thr307Ala or p. Asn680Ser coding sequence change and PCOS. The variant homozygote genotype results in a higher risk of PCOS. PMID: 28547204
- The evaluation of sperm DNA fragmentation as a surrogate marker of sperm quality, and of the FSHR SNP rs6166 (p.N680S), might be useful to predict the response to FSH treatment in men with idiopathic infertility PMID: 27329968
- Mouse chondrocytes and human articular cartilage express functional FSHR. Moreover, FSH can act on chondrocytes and cause genetic changes. PMID: 29133260
- The mutation p.R59X in FSHR is causative for primary ovarian insufficiency by means of arresting folliculogenesis. PMID: 29157895
- two mutations, V(221)G and T(449)N, in the extracellular domain and transmembrane helix 3, of FSHR, respectively, are reported. PMID: 27889471
- The reduced fertilisation and pregnancy rate was associated with a lower LH receptor density and a lack of essential down-regulation of the FSH and LH receptor. PMID: 28188844
- This work demonstrates that the expression of FSHR and LHCGR can be induced in hGL5 cells but that the FSHR-dependent cAMP/PKA pathway is constitutively silenced, possibly to protect cells from FSHR-cAMP-PKA-induced apoptosis. PMID: 27502035
- The incidence of the Ser/Ser genotype was higher in patients with higher recombinant human follicle-stimulating hormone consumption. Based on our results, we hypothesize an association between the follicle-stimulating hormone receptor polymorphisms and a "hyporesponse" to exogenous follicle-stimulating hormone. PMID: 26902430
- The data suggest novel follicle-stimulating hormone receptor expression in endometriotic lesions, qualitatively and quantitatively different from that of normal endometrium. PMID: 26704526
- Novel mutations, c.419delA and c.1510C>T of the FSHR gene were associated with resistant ovarian syndrome. PMID: 28397217
- Association of the FSHR G-29A, 919A > G, 2039A > G polymorphisms with male infertility in Han-Chinese PMID: 28764642
- A polymorphism within the promoter of FSHR is determined to not be associated with ovarian reserve or response to controlled ovarian hyperstimulation. PMID: 27448492
- Description of a novel functional FSHR expression, where FSH-stimulated CYP19A1 expression and estrogen production in recto-vaginal endometriotic nodules (RVEN) are demonstrated. This locally FSH-induced estrogen production may contribute to the pathology, development, progression, and severity of RVEN . PMID: 27224263
- N680S FSHR gene polymorphism affects the efficacy of recombinant versus highly purified follicle-stimulating hormone. PMID: 26959715
- The results of this study demonstrate that the genetic combination of A/G for polymorphism c.2039 with G/G for polymorphism c.-29 of the FSHR gene is significantly associated with the highest number of collected oocytes (p = 0.03). This association was significant even after controlling for the effect of other clinical variables PMID: 27817039
- Data suggest that both sisters exhibiting primary ovarian failure are homozygous for a previously unreported missense mutation (c.1222G.T, p.Asp408Tyr) in the second transmembrane domain of FSHR; consanguinity in this Turkish family was reported. [CASE REPORT] PMID: 26911863
- The luteinizing hormone/human chorionic gonadotrophin receptor (LHCGR) variant N312S and the follicle-stimulating hormone receptor (FSHR) variant N680S can be utilized for the prediction of pregnancy chances in women undergoing IVF. PMID: 26769719
- The role of FSHR gene variants (SNPs in exon 10 (codon 307 and 680) and in the core promoter region (at position -29) and Ala189Val inactivating mutation) in Turkish infertile women PMID: 26404793
- Ala307Thr polymorphism in FSHR can be potentially associated to primary ovarian insufficiency development and can be considered as a screening marker in patients with ovarian failure signals. PMID: 26291798
- The Asn680Ser polymorphism within the FSHR gene was not associated with endometriosis and infertility. PMID: 25935136
- Our studies further confirmed reports that there were no significant associations between the FSHR Thr307Ala and Asn680Ser polymorphisms and male infertility risk. However, a combined FSHR genotype showed significant association with male infertility. PMID: 26125757
- Endothelial FSHR expression in breast cancer is associated with vascular remodeling at tumor periphery. PMID: 25652007
- The extracellular loop 2 (EL2) of FSH receptor (FSHR) plays a pivotal role in various events downstream of FSH stimulation. PMID: 25791375
- the hinge region and its adjacent domains have roles in binding and signaling patterns of the thyrotropin and follitropin receptor PMID: 25340405
- This study demonstrate that the two common FSHR polymorphisms FSHR 307 and FSHR 680 affect FSH-induced granulosa cell responses in human small antral follicles. PMID: 25403644
- Girls homozygous for FSHR -29AA (reduced FSH receptor expression) entered puberty 7.4 (2.5-12.4) months later than carriers of the common variants FSHR -29GG+GA. PMID: 25231187
- This is the first study to confirm the association of novel LHCGR and FSHR SNPs with PCOS. The differential association of LHCGR and FSHR variants with PCOS confirms the racial/ethnic contribution to their association with PCOS. PMID: 25649397
- Follicle-stimulating hormone receptor gene polymorphism at position 680 is associated with different ovarian responses to controlled ovarian hyperstimulation PMID: 25132286
- the present study suggested that the FSHR polymorphisms were not associated with an increased risk of polycystic ovary syndrome PMID: 25218548
- The distributions of FSHR polymorphisms may not have an effect on endometriosis development but they are associated with the severity of the disease. PMID: 25502184
- The role of the N680S FSHR polymorphism in ovarian response to ovarian stimulation. [Meta-analysis] PMID: 25526787
- A novel pathogenic variant in FSHR (c.1253T>G, p.Ile418Ser), inherited as an autosomal recessive trait from heterozygous parents responsible for premature ovarian failure. PMID: 25875778
顯示更多
收起更多
-
相關疾病:Ovarian dysgenesis 1 (ODG1); Ovarian hyperstimulation syndrome (OHSS)
-
亞細胞定位:Cell membrane; Multi-pass membrane protein.
-
蛋白家族:G-protein coupled receptor 1 family, FSH/LSH/TSH subfamily
-
組織特異性:Sertoli cells and ovarian granulosa cells.
-
數據庫鏈接:
Most popular with customers
-
-
YWHAB Recombinant Monoclonal Antibody
Applications: ELISA, WB, IHC, IF, FC
Species Reactivity: Human, Mouse, Rat
-
Phospho-YAP1 (S127) Recombinant Monoclonal Antibody
Applications: ELISA, WB, IHC
Species Reactivity: Human
-
-
-
-
-